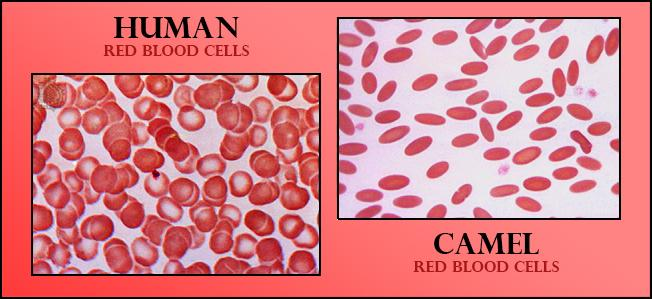
seo images

The RBCs of the camel are
A. Circular, convex and non-nucleated
B. Circular, convex and nucleated
C. Oval and non-nucleated
D. Oval and nucleated
Answer
618k+ views
Hint: The RBCs of camels are similar to the other mammals with the difference in the shape of the RBC, and the presence or absence of a nucleus.
Complete answer:
Like all mammals, camel's red blood cells do have the nucleus, that is they are nucleated and are oval instead of a round shape.
Additional Information:
-When the RBCs are developing in the red bone marrow, they do have nuclei. However, these nuclei are ejected from the cells when they enter the bloodstream in a process known as enucleation.
-In camels, the process of enucleation does not take place hence they have nucleated red blood cells.
-In camels, the erythrocytes or red blood cells are oval because the oval shape of the cell can circulate through thick blood and can expand during dehydration.
-The camel’s RBCs can be aligned in the various directions of the blood without any complications.
-The red blood cells of camels can expand to 240% of their initial size which as a result can hydrate their blood much more when allowed to drink water.
-In mammals, the RBC is generally binucleated, without the nucleus and the mitochondria.
-In mammals, the red blood cells do not contain any cell organelles making it rich in hemoglobin.
So, the correct answer is ‘Oval and nucleated’.

Note: Mammalian erythrocytes are typically biconcave discs shaped, flattened, and depressed in the center. This shape optimizes the flow properties of blood in the large vessels. However, there are certain exceptions concerning shape including cattle, deer; small and highly ovaloid cells in llamas and camels; tiny spherical cells in mice.
Complete answer:
Like all mammals, camel's red blood cells do have the nucleus, that is they are nucleated and are oval instead of a round shape.
Additional Information:
-When the RBCs are developing in the red bone marrow, they do have nuclei. However, these nuclei are ejected from the cells when they enter the bloodstream in a process known as enucleation.
-In camels, the process of enucleation does not take place hence they have nucleated red blood cells.
-In camels, the erythrocytes or red blood cells are oval because the oval shape of the cell can circulate through thick blood and can expand during dehydration.
-The camel’s RBCs can be aligned in the various directions of the blood without any complications.
-The red blood cells of camels can expand to 240% of their initial size which as a result can hydrate their blood much more when allowed to drink water.
-In mammals, the RBC is generally binucleated, without the nucleus and the mitochondria.
-In mammals, the red blood cells do not contain any cell organelles making it rich in hemoglobin.
So, the correct answer is ‘Oval and nucleated’.
Note: Mammalian erythrocytes are typically biconcave discs shaped, flattened, and depressed in the center. This shape optimizes the flow properties of blood in the large vessels. However, there are certain exceptions concerning shape including cattle, deer; small and highly ovaloid cells in llamas and camels; tiny spherical cells in mice.
Recently Updated Pages
Master Class 11 Social Science: Engaging Questions & Answers for Success

Master Class 11 Chemistry: Engaging Questions & Answers for Success

Class 7 Question and Answer - Your Ultimate Solutions Guide

Master Class 6 English: Engaging Questions & Answers for Success

Master Class 6 Maths: Engaging Questions & Answers for Success

Master Class 6 Science: Engaging Questions & Answers for Success

Trending doubts
One Metric ton is equal to kg A 10000 B 1000 C 100 class 11 physics CBSE

Difference Between Prokaryotic Cells and Eukaryotic Cells

Two of the body parts which do not appear in MRI are class 11 biology CBSE

Explain zero factorial class 11 maths CBSE

10 examples of friction in our daily life

Name the Largest and the Smallest Cell in the Human Body ?




